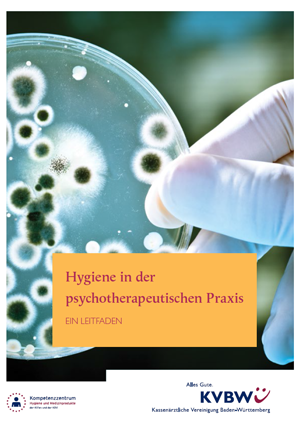

Themenauswahl
- Anlässlich ihres Doppeljubiläums – 20 Jahre KVBW und 80 Jahre KV im Südwesten – publizierte die KVBW ein Jubiläumsmagazin mit Artikeln, Interviews und Infografiken rund um die KVBW und die Gesundheitsversorgung. Thematisch gegliedert nach dem Jubiläumsmotto: Gestern. Heute. Morgen.